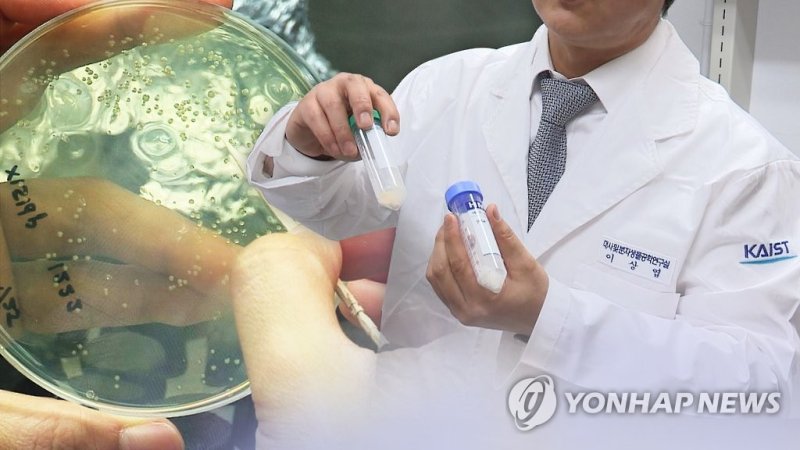

5년간 172억원 투입…"바이오플라스틱 등 저탄소 전환 가속화"
산업부, '바이오공정 기반 탄소순환 플랫폼' 시범사업 착수5년간 172억원 투입…"바이오플라스틱 등 저탄소 전환 가속화"
(서울=연합뉴스) 김동규 기자 = 산업통상자원부는 12일 충남 서산 베니키아호텔에서 '바이오 공정 기반 전주기 탄소순환 플랫폼 기술 개발' 시범사업 추진을 위해 사업 수행기관 간 업무협약(MOU)을 체결했다고 밝혔다.
협약에는 한국바이오협회, 서산시, 탄소순환 플랫폼 사업 수행 기관·기업 등 14곳이 참여했다.
참여 기관·기업들은 탄소순환 플랫폼 도입 기반 조성, 시범사업 운영 및 데이터 공유, 화이트 바이오 산업 생태계 구축 지원 등을 위해 협력하기로 했다.
이날 협약을 시작으로 사업단은 서산시 공공기관과 시설, 지역 축제 현장 등을 대상으로 분리수거 선별시스템, 바이오 가스화, 플라스틱 퇴비화, 통합공정 전과정평가(LCA) 등 탄소순환 플랫폼 기술을 적용한 실증을 진행하기로 했다.
이 시범사업에는 2029년까지 5년간 172억원의 국비가 투입된다.
정부는 지방자치단체와 민간의 협력을 통해 성공 모델을 도출한다는 방침이다.
산업부 관계자는 "이번 시범사업이 국내 화이트 바이오 산업 육성을 위한 기반을 마련하고, 바이오플라스틱 등 친환경 제품 제조를 확대해 친환경·저탄소 중심의 산업구조 전환을 앞당길 것으로 기대한다"고 말했다.
dkkim@yna.co.kr
(끝)
<저작권자(c) 연합뉴스, 무단 전재-재배포, AI 학습 및 활용 금지>
※ 저작권자 ⓒ 연합뉴스, 무단전재-재배포 금지